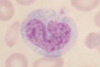
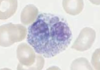

Innate immunity Flashcards
(38 cards)
What are the 3 phases of response to initial infection and what are their timescales?
- Innate immunity: 0-4 hours
- Early induced response: 4-96 hours
- Adaptive immune response: >96 hours
What happens in 0-4 hours of infection?
- Innate immunity
- Recognition of infection by nonspecific effectors
- Removal of the infectious agent
What happens in 4-96 hours of infection?
- Early induced response
- Recruitment of effect cells
- Recognition and activation of effector cells
- Removal of infectious agent
What happens after 96 hours of infection?
- Adaptive immune response?
- Transport of antigen to lymphoid organs
- Recognition by naive B and T cells • Clonal expansion of effector cells
- Removal of infectious agent
What are the mechanical barriers to infection?
- Tight junctions between cells prevent access
- Air and fluid flow across the epithelium
- Movement of mucus by cilia
What are the chemical barriers to infection?
- Fatty acids on the skin
- Enzymes: lysozyme in saliva, sweat and tears
- Low pH in stomach
- Antibacterial peptides: defensins (skin and gut) and cryptidins (gut)
what are the microbiological barriers to infection?
- normal flora compete for nutrients and attachment (biofilms)
- Normal flora produce antibacterial substances (colicins)
What types of cells ingest micro-organisms once across the epithelial barrier?
- Mononuclear phagocytes
- Macrophages
What receptors recognise microorganisms for ingestion?
- Mannose receptor
- Glucan receptor
- Scavenger receptor
- CD14 (LPS)
- CD11v/CD18 (CR3)
Describe the environment of a phagosome
- pH of 3-4
- Toxic oxygen derived products: superoxide, hydrogen peroxide, hydroxyl radical
- Toxic nitrogen oxides: nitric oxide
- Peptides: defensins and other cationic proteins
- Enzymes: lysozyme, acid hydrolases
- Competitors: lactoferrin, vitamin B12 binding protein
What are the two pathways for bone marrow relating to the immune response?
Myeloid:
- Polymorphonuclear leukocytes
- neutrophils, basophils, eosinophils
Common lymphoid progenitor:
- B cells
- T cells
What are the effects of IFN alpha and beta?
- Induce resistance to viral replication in all cells
- Increases MHC class 1 expression and antigen presentation in all cells
- Activation of NK cells to kill virus infected cells
Why are natural killer cells important at the start of the immune response?
- Not specific
- Don’t require a lengthy clonal expansion of T cells in lymph nodes
What dictates if a natural killer cell is active?
- Balance between signals
- A positive signal to kill can be overridden by a negative signal by MHC molecules (inhibitory)
What is the complement system?
A cascade of serum proteins in the bloodstream
What are the 3 ways of triggering the complement cascade?
1) Classical Pathway: Antibody binds to a specific antigen on the pathogen surface
2) Lectin pathway; Mannose-binding protein binds to the pathogen surface
3) Alternative pathway: Pathogen surface creates environment conducive to complement activation
What does the activation of the complement cascade lead to?
- Recruitment of mediators of inflammation, phagocyte recruitment
- Opsonization of pathogens, facilitating uptake and killing by phagocytic cells
- Lysis and death of pathogens
What is C3b?
An opsonin
What is C3a?
Peptide mediator of inflammation
What is C5a?
Peptide mediator of inflammation
Describe how the classical pathway of the complement system is initiated
By C1r C3 splits into C3a, which floats away and is a mediator of inflammation, and C3b which acts as an opsonin
How is the alternative pathway of the complement system initiated?
The spontaneous hydrolysis of serum C3 Triggered by something on the bacterial surface
What forms MAC and what does it do?
- C5b, C6 and C7
- Self assembly
- Punctures a hole in the surface of the bacteria causing the inner contents to leak out
- Direct lysis of the bacteria
What regulates complement activity?
- DAF: Decay accelerating factor
- MCP: membrane cofactor protein
- CR 1: Complement receptor 1